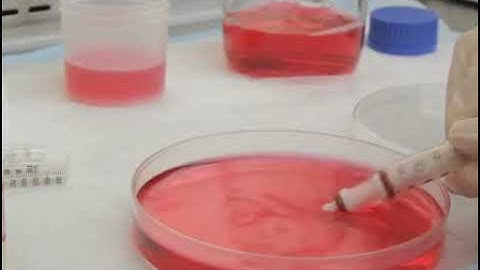
Utilization of fibrin hydrogel for the encapsulation of cardiomyocytes in cardiac tissue engineering

⬇ DOWNLOAD NOW
Kalau muncul iklan pop-up, tutup lalu klik tombol kembali
Download lagu Understanding Advanced Cardiac Tissue Slice Applications secara gratis hanya untuk keperluan promosi. Dukung artis favorit kamu dengan membeli musik original di iTunes atau platform resmi lainnya.
 Cardiac Tissue Slices to Model Cardiac Health and Disease in Culture | by Dr. Tamer Mohamed
Cardiac Tissue Slices to Model Cardiac Health and Disease in Culture | by Dr. Tamer Mohamed
 Human Heart Slice – Next Generation of Cardiotoxicity Testing Platform | AnaBios Webinar
Human Heart Slice – Next Generation of Cardiotoxicity Testing Platform | AnaBios Webinar
 Cardiac Tissue Slices: Preparation, Data Acquisition, and Analysis
Cardiac Tissue Slices: Preparation, Data Acquisition, and Analysis
 Cardiovascular System: Cardiac Tissue Histology
Cardiovascular System: Cardiac Tissue Histology
 Myocytes from adult rat hearts, in primary culture
Myocytes from adult rat hearts, in primary culture
 Cardiac myocyte 3D animation: the heart’s powerhouses
Cardiac myocyte 3D animation: the heart’s powerhouses
 Dynamic Models of Human-Engineered Heart Tissue
Dynamic Models of Human-Engineered Heart Tissue
Utilization of fibrin hydrogel for the encapsulation of cardiomyocytes in cardiac tissue engineering
Utilization of fibrin hydrogel for the encapsulation of cardiomyocytes in cardiac tissue engineering